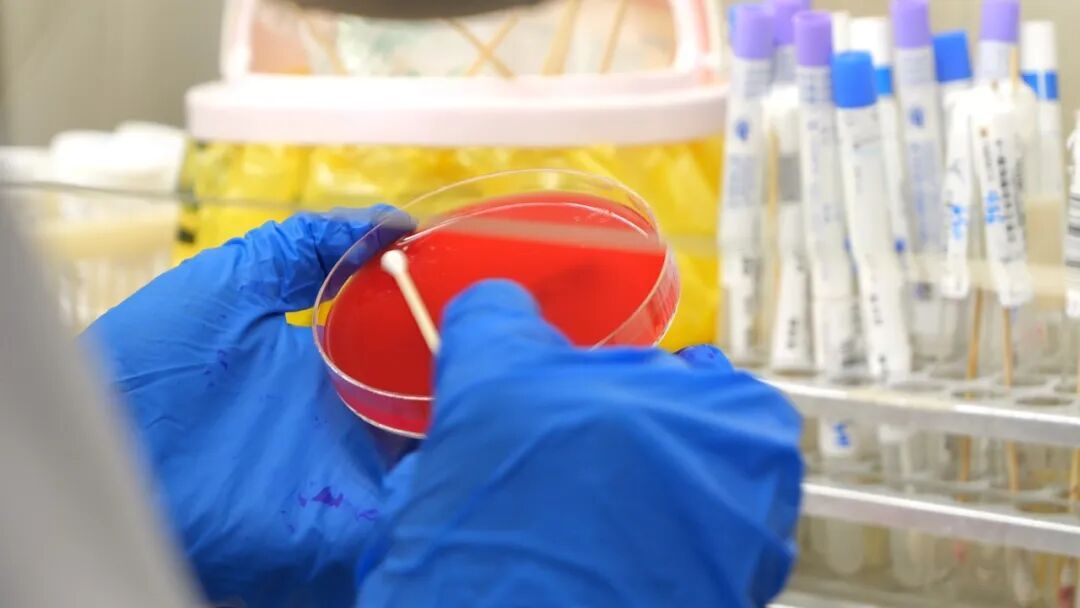

发热就诊不便,担心交叉感染?2026年1月起,仁济医院嘉定分院(嘉定区中心医院)联合京东健康,启动“呼吸道病原体到家快检”服务。医院周边8公里范围内,只需在网上一键预约,执业护士按预约时间上门,在家就能搞定检测、开药等问题。
近日,市民陈女士三岁的孙女小杺连续几天反复高烧,精神不振。全家人心急如焚,想立刻带孩子去医院查明病因,但一想到医院门诊人流密集,身体免疫力较弱的小杺可能面临交叉感染的风险,又陷入了深深的犹豫。
了解到了“呼吸道病原体到家快检”服务,陈女士马上在京东App上下单,仅过半个小时左右,京东健康的执业护士就带着工具箱上门。在熟悉的家庭环境中,小杺情绪相对稳定,顺利完成了鼻拭子和咽拭子采样。检测样品第一时间由闪送骑手送往仁济医院嘉定分院(嘉定区中心医院)进行化验。

约两个小时后,由仁济医院嘉定分院(嘉定区中心医院)出具的详细检测报告已经发送至下单者的手机。报告显示,小杺确诊为甲流,而在检测报告界面,执业医生报告解读、用药建议等内容也清晰可见。
“真是帮我们解决了一个大难题!和以前去医院排队挂号相比方便太多了,只要上网预定一下,医护人员就上门来检测了,结果出得快,配好的药也可以直接快递到家里来,避免去医院交叉感染了,安心了许多。”陈女士说道。
记者了解到,本次“到家快检”服务共开放了6项呼吸道病原体检查,覆盖甲流、乙流、合胞病毒、鼻病毒、腺病毒、肺炎支原体。通过一次上门采样,即可实现对多种病原体的同步检测与鉴别。检测采用PCR核酸检测技术,确保结果准确可靠。
“到家快检”服务启动以来,已经接收到了不少良性反馈。仁济医院嘉定分院(嘉定区中心医院)智慧发展中心主任迟辰斐介绍:“它有效衔接了家庭初诊与精准医疗,在减少人群聚集、降低交叉感染风险的同时,为行动不便或有特殊顾虑的患者群体提供了高效、便捷、安全的新选择。”

本次仁济医院嘉定分院(嘉定区中心医院)与京东健康的“牵手服务”,离不开嘉定与京东的深度合作。京东健康作为全国领先的医疗健康商品、服务、解决方案提供商,覆盖医药健康全产业链、医疗全流程、健康全场景、用户全生命周期。2025年6月,京东健康项目落地嘉定,包括京东秒送大药房业务和京东医药项目,依托线下自营药店和线上平台,探索创新医疗保障服务新模式,进一步满足上海用户对便捷医疗服务购药的需求。
“后续我们计划提供更多的上门检测服务,包括常规的验血、血常规等服务,为广大市民提供更多专业便利的医疗服务。”迟辰斐表示。
如何线上下单?
打开京东APP搜索“嘉定区中心医院”,选择所需检测项目(如新冠/甲乙流联检、呼吸道病原体6联检等),一分钟轻松下单。
如检测结果为阳性,可凭报告快速预约嘉定区中心医院门诊,省去院内排队等候,减少交叉感染风险。


也可通过互联网医院直接对接医院专科医生,在线沟通诊疗方案、开具处方,同步安排配药送药到家。
互联网医院进入方式:扫描下方二维码,或者微信搜索“嘉定区中心医院”服务号,点击【就诊服务】→【互联网医院】。


温馨提示
本检测服务为自费项目,急重症患者请及时前往医院急诊就医。







点赞分享给身边的人